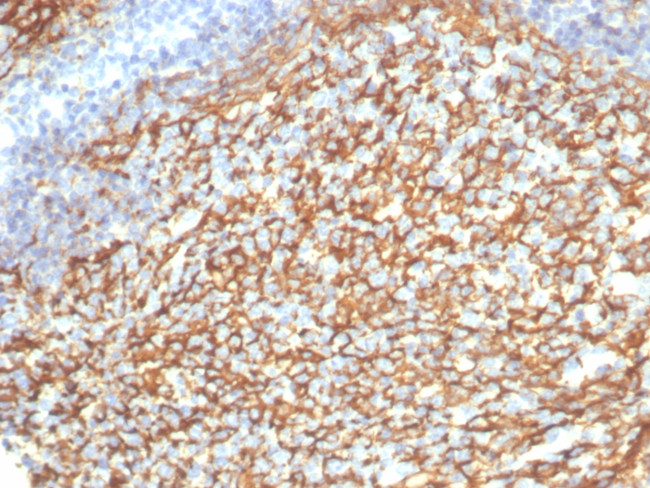
CD21 (Mature B-Cell and Follicular Dendritic Cell Marker) Antibody in Immunohistochemistry (Paraffin) (IHC (P))

Search
NeoBiotechnologies
CD21 (Mature B-Cell and Follicular Dendritic Cell Marker) Recombinant Rabbit Monoclonal Antibody (CR2/7185R)
{{$productOrderCtrl.translations['antibody.pdp.commerceCard.promotion.promotions']}}
{{$productOrderCtrl.translations['antibody.pdp.commerceCard.promotion.viewpromo']}}
{{$productOrderCtrl.translations['antibody.pdp.commerceCard.promotion.promocode']}}: {{promo.promoCode}} {{promo.promoTitle}} {{promo.promoDescription}}. {{$productOrderCtrl.translations['antibody.pdp.commerceCard.promotion.learnmore']}}
产品信息
1380-RBM15-P0
种属反应
宿主/亚型
Expression System
分类
类型
克隆号
抗原
偶联物
形式
浓度
规格
纯化类型
保存液
内含物
保存条件
运输条件
靶标信息
CD21 (complement receptor 2, CR2, C3D receptor, EBV receptor) binds C3 complement fragments, especially its breakdown fragments, which remain covalently attached to complement activating surfaces or antigen. CD21 has important roles in uptake and retention of immunocomplexes, survival of memory B cells and in development and maintenance of the humoral response to T-dependent antigens. CD21 also serves as a key receptor for Epstein-Barr virus binding and is involved in targeting prions to follicular dendritic cells and expediting neuroinvasion following peripheral exposure to prions. A soluble form of the CD21 (sCD21) is shed from the lymphocyte surface and retains its ability to bind respective ligands. CD21 functions as receptor for C3d, C3dg and iC3b complement components, for EBV and for IFNalpha. CD21 binds to CD23 and associates with CD19, CD81 and Leu13 to form a large signal-transduction complex involved in B cell activation. Genetic variations in the CD21 gene are associated with susceptibility to systemic lupus erythematosus type 9 (SLEB9). Alternatively, spliced transcript variants encoding different isoforms of CD21 have been found.
仅用于科研。不用于诊断过程。未经明确授权不得转售。
篇参考文献 (0)
生物信息学
蛋白别名: CD21; Complement C3d receptor; Complement C3d receptor (C3DR); complement component (3d/Epstein Barr virus) receptor 2; complement component 3d receptor 2; Complement receptor type 2; Complement Receptor type 2 (CR2); Cr2; CR2 precursor; CR2/CD21/C3d/Epstein-Barr virus receptor precursor; EBV receptor; EBV-R; Epstein-Barr virus receptor; EVBR; unnamed protein product
基因别名: C3DR; CD21; CR; CR2; CVID7; SLEB9
UniProt ID: (Human) P20023
Entrez Gene ID: (Human) 1380